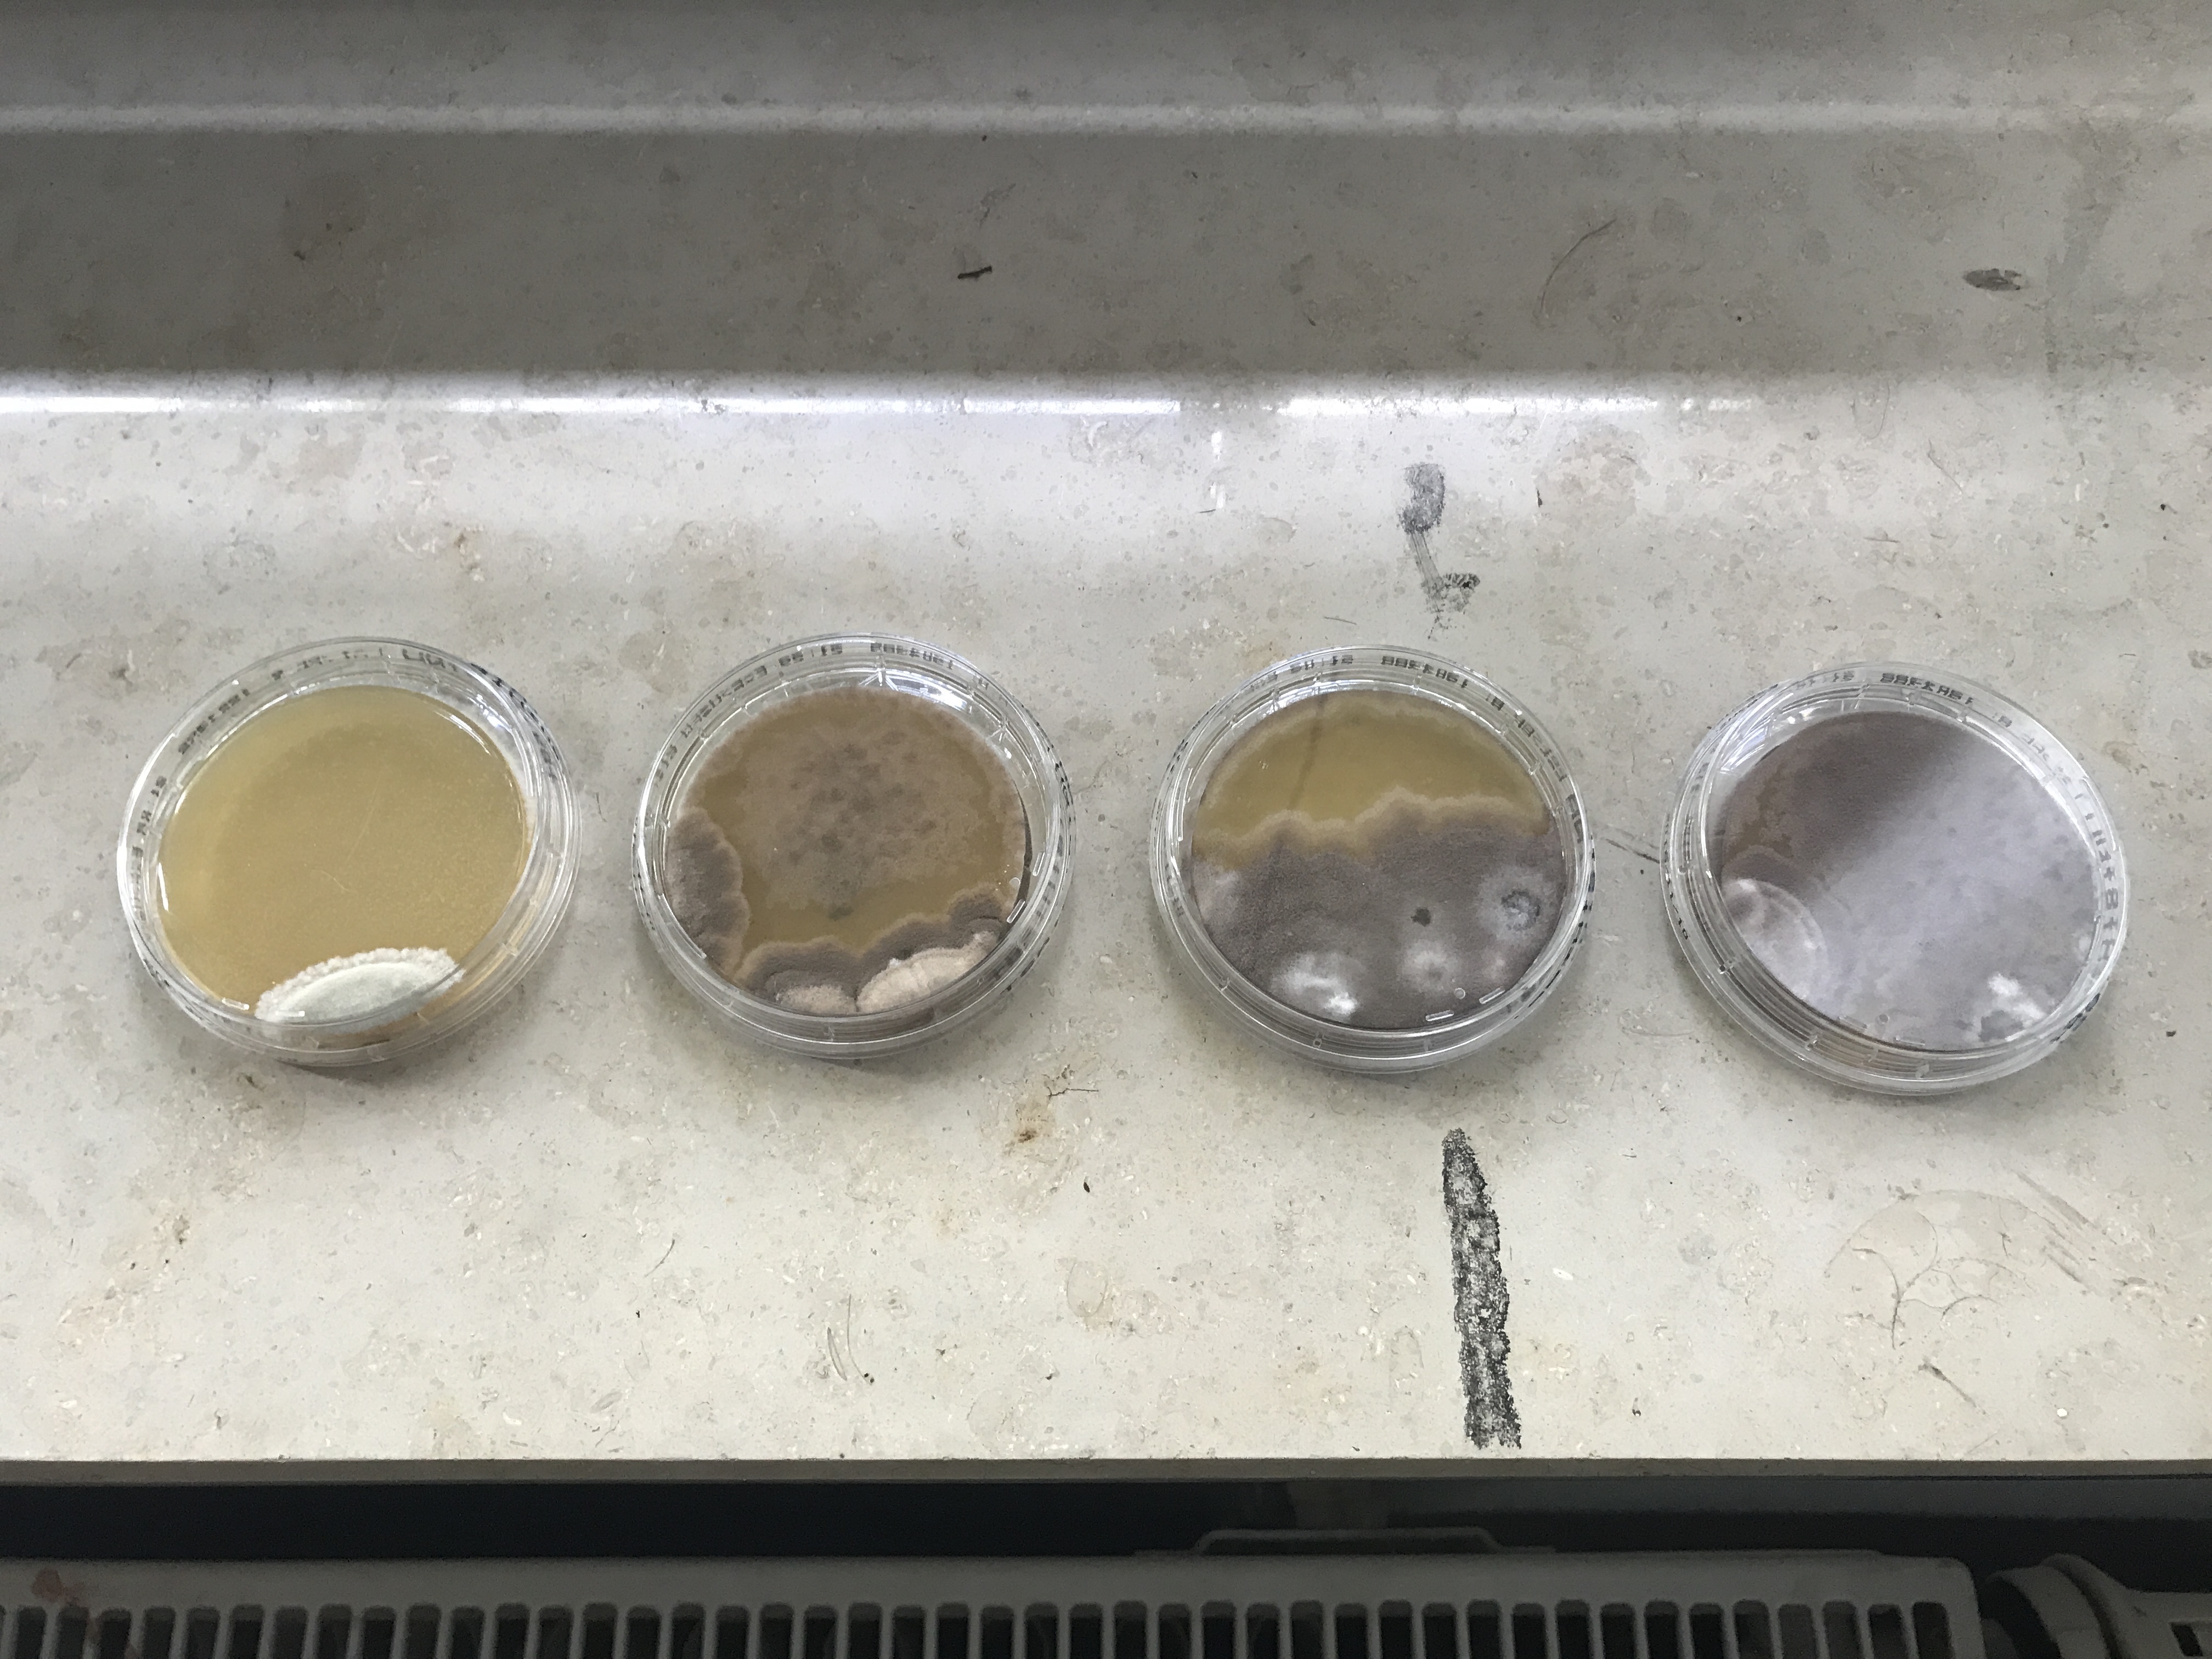
2

Kontakt
Versicherung
Reser Spezialreinigungen
Adresse: Sonnenleite 43, DE 09117 Chemnitz
Telefon: +49(0)1633317444

Geschäftszeiten
Mo:
09:00:00 bis 17:00:00
Di:
09:00:00 bis 17:00:00
Mi:
09:00:00 bis 17:00:00
Do:
09:00:00 bis 17:00:00
Fr:
09:00:00 bis 17:00:00
Sa:
geschlossen
So:
geschlossen
Über uns
Reser Spezialreinigungen aus Chemnitz ist Ihr Ansprechpartner für
Hygieneinspektionen und wirkungsvolle Spezialreinigungen. Wir prüfen und
bewerten RLT Anlagen nach VDI 6022, führen Luftkeimmessungen durch und
dokumentieren den Zustand von Zu und Abluftkanälen per Kamerainspektion.
So erhalten Sie klare Ergebnisse und schaffen sichere, hygienische Raumluft
für Mitarbeitende und Kunden. Für besonders hartnäckige Rückstände bieten
wir zudem mobile Laserreinigung, eine präzise, materialschonende Methode
zur Entfernung von Rost, Beschichtungen und Verschmutzungen. Schnell,
zuverlässig und regional in Chemnitz und Umgebung.
Gründungsjahr: 2000
Unsere Dienstleistungen / Services
- Desinfektion
- Geruchsneutralisierung
- Trockendampfreinigung
- Kamerainspektionen
- Reinigung von Prozessabluftanlagen
- Reinigung nach VDI 6022
- Reinigung nach VDI 2052
- Fußbodengrundreinigung
- Glasreinigung
- Hygieneinspektionen
- Solaranlagenreinigung
- Fettabscheiderentleerung
- Außenjalousien und Rollladenreinigung
- Kanalbeschichtungen
- Mobile Laserreinigung
Unsere Bezahlmöglichkeiten
- Bargeld
- Cash
- Banküberweisung
Suchwörter
- Hygieneinspektion RLT Anlagen
- RLT Anlagen Reinigung
- RLT Hygieneinspektion nach VDI 6022
- VDI 6022 Inspektion
- Luftkeimmessung RLT
- Raumlufttechnik Reinigung
- Lüftungsanlagen Reinigung
- Lüftungskanäle reinigen
- Abluftanlage reinigen
- Zuluftkanal Reinigung
- Desinfektion Lüftungsanlage
- Raumluft Hygieneprüfung
- Industriewartung Lüftungsanlagen
- mobile Laserreinigung
- Laserreinigung Metall
- Rost entfernen mit Laser
- Beschichtung entfernen Laser
- industrielle Laserreinigung
- Trockeneisreinigung Industrie
- Spezialreinigung Industrieanlagen
- Hygieneinspektion Chemnitz
- Hygieneinspektion
- RLT Reinigung Chemnitz
- Lüftungsanlagen Reinigung Chemnitz
- Laserreinigung Chemnitz
- mobile Laserreinigung Chemnitz
- VDI 6022 Chemnitz
- Luftkeimmessung Chemnitz
- Spezialreinigungen Chemnitz
- Industriekunden Reinigung Sachsen
- RLT Wartung Sachsen